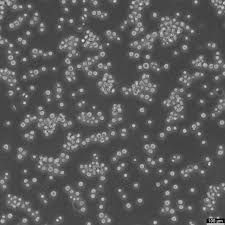

Jurkat cells are one of the most extensively used immortalized cell lines in research. Originally derived from the peripheral blood of a 14-year-old boy with acute T-cell leukemia, these cells have become a critical model for studying T-cell function, immune responses, apoptosis, and the molecular mechanisms underlying leukemia and lymphoma. Cytion.com offers a wide range of high-quality Jurkat cells, providing researchers with the essential tools needed to explore the complexities of T-cell biology, cancer, and immunotherapy.
This article aims to explore the background, applications, and significance of Jurkat cells, with a focus on their role in immunology and cancer research, and how Cytion's Jurkat cells can support scientific advancements in these areas.
What Are Jurkat Cells?
Jurkat cells are an immortalized human T lymphocyte cell line that was first established in 1975. These cells are derived from the peripheral blood of a patient with T-cell leukemia and are widely recognized for their consistent behavior and easy propagation in laboratory conditions. As a transformed cell line, Jurkat cells exhibit several characteristics that make them ideal for research in areas like immunology, signal transduction, and cancer biology.
These cells are specifically used to model CD4+ T cells, a subset of T lymphocytes that play a central role in the immune system. Jurkat cells are known to respond to various signaling stimuli, such as cytokines and growth factors, and are particularly useful for studying the activation of T cells, T-cell receptor (TCR) signaling pathways, and apoptosis mechanisms.
The Significance of Jurkat Cells in Immunology
Immunology has benefited greatly from the use of Jurkat cells. The cell line's ability to mimic the behavior of primary T-cells has allowed researchers to study the complex processes involved in immune activation, signaling, and regulation. Specifically, Jurkat cells are employed in experiments designed to investigate T-cell receptor (TCR) signaling, cytokine production, and the molecular pathways that govern T-cell activation.
T-Cell Activation and Signaling
Jurkat cells have become a standard model for studying T-cell activation, which is essential for initiating an adaptive immune response. The TCR is critical in recognizing antigens presented by major histocompatibility complex (MHC) molecules on antigen-presenting cells (APCs). When activated, TCR signaling triggers a cascade of intracellular signaling pathways that lead to T-cell proliferation, differentiation, and cytokine production.
By exposing Jurkat cells to various stimuli, such as specific antigens, cytokines, or pharmacological inhibitors, researchers can study how these signals activate key molecules involved in immune responses. Cytion’s high-quality Jurkat cells, known for their reliability and reproducibility, are widely used for analyzing signaling molecules like protein kinase C (PKC), mitogen-activated protein kinases (MAPKs), and phosphoinositide 3-kinase (PI3K), which play critical roles in T-cell activation and function.
Apoptosis and Immune Regulation
Another significant application of Jurkat cells in immunology is studying apoptosis, the programmed cell death mechanism. Apoptosis is crucial in regulating immune responses by eliminating defective or infected cells and preventing the development of autoimmune diseases. In T cells, apoptosis can be triggered by various stimuli, including cytokines, changes in the cellular environment, or TCR signaling.
Jurkat cells serve as an ideal model for studying the molecular mechanisms of apoptosis because they respond predictably to apoptotic signals. Researchers can manipulate various factors, such as overexpressing pro-apoptotic or anti-apoptotic genes, to study how these proteins influence the survival of T cells. Furthermore, Jurkat cells are used to explore the roles of signaling molecules like caspases, Bcl-2 family proteins, and death receptors in regulating apoptosis.
Jurkat Cells in Cancer Research
In addition to their applications in immunology, Jurkat cells play a vital role in cancer research, particularly in the study of T-cell leukemia and lymphoma. The cell line is used to model T-cell malignancies, including acute T-cell leukemia, and to explore the molecular mechanisms driving these diseases. T-cell leukemia is a type of blood cancer that results from the uncontrolled proliferation of T lymphocytes, and it has been difficult to treat with existing therapies.
T-cell leukemia and Lymphoma
Jurkat cells are particularly important in studying T-cell leukemia due to their origin from a patient with this condition. The cells harbor several mutations that contribute to the uncontrolled proliferation and survival of malignant T cells. By studying Jurkat cells, researchers can identify the genetic and epigenetic factors that drive leukemia, such as alterations in oncogenes, tumor suppressor genes, and cell cycle regulators.
Moreover, Jurkat cells are used to investigate how T-cell leukemia cells evade apoptosis and proliferate in response to cytokines and growth factors. This knowledge is essential for developing targeted therapies that can disrupt the survival signals and induce cell death in T-cell leukemia.
Additionally, Jurkat cells are often employed to study the mechanisms of immune evasion in cancer. Tumors can manipulate immune cells to suppress their function, allowing cancer cells to escape detection and elimination. Understanding how cancer cells affect immune signaling pathways is critical for the development of immunotherapies that can enhance the body’s immune response against tumors.
Drug Discovery and Screening Using Jurkat Cells
Jurkat cells are widely utilized in drug discovery and screening assays due to their consistent behavior and predictable responses to external stimuli. In pharmaceutical research, Jurkat cells are used to identify compounds that can modulate T-cell activation, immune responses, or cancer cell survival.
For example, Jurkat cells are employed to test potential immunomodulatory drugs that could enhance or suppress T-cell activity. These assays are crucial for developing treatments for autoimmune diseases, such as rheumatoid arthritis or multiple sclerosis, as well as therapies aimed at boosting immune function in cancer patients.
Moreover, Jurkat cells serve as a useful platform for evaluating drugs targeting T-cell signaling pathways, including those involved in cancer and immune disorders. Through these assays, researchers can assess the effects of specific compounds on key signaling proteins, such as kinases, phosphatases, and transcription factors, which are crucial in regulating T-cell function.
Jurkat Cells in Gene Editing and Biotechnology
Another exciting application of Jurkat cells is in gene editing and biotechnology. With the advent of technologies like CRISPR-Cas9, researchers can modify the DNA of Jurkat cells to study the effects of specific genes on T-cell behavior. This allows scientists to manipulate signaling pathways, immune responses, and even the progression of T-cell malignancies.
Jurkat cells are also used to express recombinant proteins, antibodies, and cytokines, which can be valuable in biopharmaceutical production. Their ability to grow in suspension culture makes them a practical choice for large-scale production of therapeutic proteins or diagnostic reagents.
Advantages of Cytion’s Jurkat Cells for Research
Cytion.com offers high-quality Jurkat cells that are meticulously characterized and validated for use in a variety of laboratory applications. The cells are known for their consistency, reproducibility, and ability to be cultured under standard laboratory conditions, making them ideal for experiments in immunology, cancer research, and drug development.
Some of the key advantages of using Cytion's Jurkat cells include:
- Reliability: Cytion’s Jurkat cells are sourced from well-established cell banks, ensuring that they maintain the same characteristics and behavior across experiments.
- Characterization: These cells are extensively tested to confirm their identity, ensuring that they retain the necessary markers and features of T lymphocytes.
- Versatility: Cytion's Jurkat cells can be used for a wide range of applications, including studying T-cell signaling, apoptosis, cancer progression, and drug testing.
- Scalability: Jurkat cells can be easily expanded and cultured in suspension, making them suitable for large-scale studies, particularly in drug screening and biopharmaceutical production.
- Quality Assurance: Cytion provides customers with high-quality, well-maintained cells, ensuring that researchers can rely on them for critical experiments without concerns over cell line stability or contamination.
Conclusion
Jurkat cells continue to be an invaluable tool for researchers studying immune responses, cancer, and T-cell biology. From their pivotal role in understanding T-cell activation and apoptosis to their applications in cancer research and drug discovery, Jurkat cells offer researchers a reliable and versatile platform for investigating a wide array of biological processes.
With Cytion’s high-quality Jurkat cells, scientists can enhance their research in immunology, cancer therapy, and biotechnology, contributing to the development of new therapeutic strategies and treatments. By providing robust, well-characterized cell lines, Cytion ensures that researchers have access to the necessary resources for groundbreaking scientific advancements. Whether you are studying immune signaling, drug responses, or cancer progression, Cytion's Jurkat cells are an essential tool for achieving meaningful results.
visit us: https://www.cytion.com/Jurkat-Cells/302147

Comments